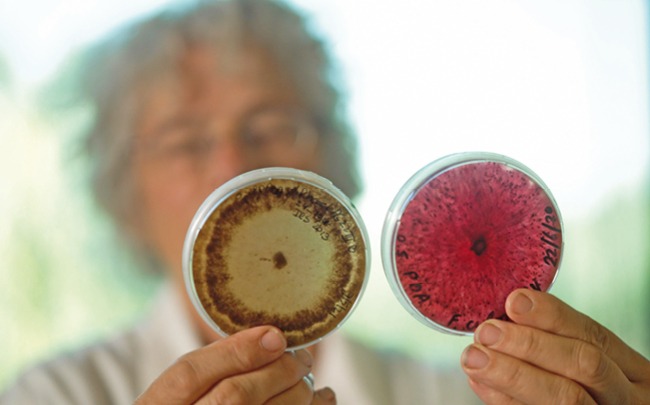

NIOO 70 jaar – Ook micro-organismen kunnen samenwerken en gewilden
tekst Froukje Rienks (NIOO-KNAW)
Van nietige losse cellen naar een rijke gemeenschap vol samenwerking. Dat is hoe het inzicht in de microwereld van bacteriën, schimmels en andere microscopisch kleine organismen zich de afgelopen twee decennia ontwikkeld heeft. Dit ‘microbioom’ op bijvoorbeeld blad en wortel en in darm en bodem heeft een enorme impact op de omgeving. Onderzoekers van het Nederlands Instituut voor Ecologie (NIOO-KNAW) kijken naar functies zoals ‘consumeren’ van broeikasgas, communicatie via geuren en hulp aan bedreigde planten.
Bestel hier het nieuwste nummer.



